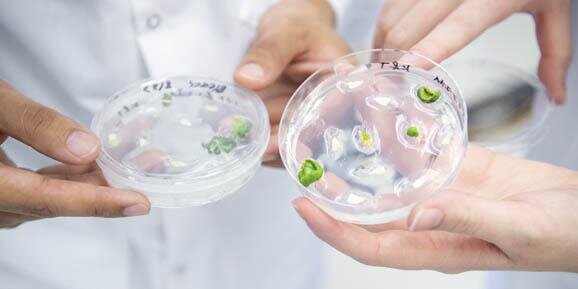

Undergraduate Major
CS+CPSC students build skills inside and outside the classroom. You’ll be among the first to analyze robotics-enabled soil and field measurements, predict weather and climate impacts on food supplies, and accelerate plant improvement through the simultaneous analysis of genetics, environment, and management.
- Develop deep knowledge and essential skills to thrive in groups of all kinds
- Address everyday and grand challenges in whatever path you pursue
- You’ll be at the forefront of research and innovation
- Fill a crucial gap in the agriculture sector
Delivery: In-Person
Department: Crop Sciences

Title
Make an Impact
Combine a strong technical background with crop sciences expertise powerful enough to change the world.Earn your degree in a supportive environment where you’ll receive the personalized attention that nurtures big dreams… for big impact.
Looking for a similar major?

Computer Science + Animal Sciences (CS+ANSC)
Pair tech skills and a love of animals to enhance animal health.
Plant Biotechnology
Learn cutting-edge plant science to develop nutritious, sustainable crops of the future.

Engineering Technology and Management for Agricultural Systems
Learn the application of engineering technology in agriculture and environmental systems.